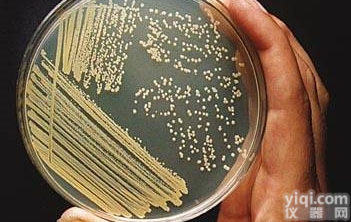
MG基本<em>培养基</em>使用<em>说明书</em>

上海古朵生物科技公司是国内elisa试剂盒优质供应商,古朵供应
金氏B培养基说明书,金氏B培养基,代理销售不同elisa试剂盒品Pai的进口/国产elisa试剂盒,专业供应科研实验所需的培养基,抗体,动物血清血浆,标准品对照品,化学试剂,酶联免疫试剂盒,白介素试剂盒,金标检测试剂盒,微生物,蛋白质,ELISA种属涵盖广,凭借多年行业经验,完善的售后服务,高质量的产品。欢迎来电咨询。
英文名称:King’s B medium
产品规格:250g
产品用途:用于铜绿假单菌产荧光色素试验
供应商:上海古朵
金氏B培养基原理:蛋白胨提供氮源;磷酸盐促进荧光素的产生并YZ绿脓色素的产生;硫*镁为荧光素的产生提供必须的阳离子;琼脂是培养基的凝固剂。
金氏B培养基用法:称取本品 38g,另取甘油 10ml,加热溶解于 1000ml 蒸馏水中,分装,121℃高压灭菌 15 分钟,备用。
金氏B培养基质量控制:在36±1℃培养24小时。
金氏B培养基说明书,金氏B培养基 储存方式:
1)干粉,买了后一定要保存在4度。有人保存在-20度我认为没有必要。但4度是非常必要的。保证期是有提示的。
2)配好的无血清培养基一定保存在4度,保存不要超过3个月。用时根据提示要加入谷胺酰胺。
3)加入血清的培养基,Z好保存在4度不要超过1个月,从时间太长,活性下降。当然稍微长点也不一定出问题。但是根据细胞而定;如果原代培养,Z好新鲜,如果是肿瘤细胞,或仅维持传代就不太要紧。但是原则是越新越好。
培养基按其物理状态可分为固体培养基、液体培养基和半固体培养基三类。营养肉汤(NB)(颗粒)
(1)固体培养基。是在培养基中加入凝固剂,有琼脂、明胶、硅胶等。固体培养基常用于微生物分离、鉴定、计数和菌种保存等方面。
(2)液体培养基。液体培养基中不加任何凝固剂。这种培养基的成分均匀,微生物能充分接触和利用培养基中的养料,适于作生理等研究,由于发酵率高,操作方便,也常用于发酵工业。
(3)半固体培养基。是在液体培养基中加入少量凝固剂而呈半固体状态。可用于观察细菌的运动、鉴定菌种和测定噬菌体的效价等方面。培养基按微生物的种类可分为细菌培养基、放线菌培养基、酵母菌培养基和霉菌培养基等四类。
金氏B培养基说明书,金氏B培养基 订购说明: 1、绝大部分产品备有现货,一般情况下都能订货当日发货。
2、部分非常用产品,需提前1-2日预订,海外期货则需要提前3-6周预订。
3、部分产品价格会因货期、批次等因素发生变化,若有变动以订货当日价格为准。
4、每日订单截止时间为16点整,部分城市可到17点整,因超过截止时间造成当日不能发货的将于次日安排发货。
5、请办理完货款后,将收据、底单等连同收货人的地址、姓名、电话等以传真、EMail、电话等形式通知我们。
金氏B培养基说明书,金氏B培养基 相关产品: CAS:556-50-3,双甘氨肽,Glycylglycine
CAS:90-05-1,愈创木酚现货
赤霉素GA4+7操作步骤
单水葡萄糖,一水葡萄糖价格
CAS:56-81-5,丙三醇(甘油)价格
CAS:50-99-7,D-无水葡萄糖现货
CAS:56-40-6,甘氨酸,氨基乙酸,氨基醋酸说明书
草铵膦/草铵磷,77182-82-2(1mg/mL)
CAS:108321-42-2,G418硫酸盐
CAS:57-09-0,十六烷基三甲基溴化铵(CTAB)
SOB培养基配方说明
4-哌嗪乙磺酸(7365-45-9)HEPES
CAS:31282-04-9,潮霉素B,Hygromycin B
CAS:53398-85-9,顺式-3-己烯醇,2-甲基丁酸酯
氨基酸螯合铁使用说明书
CAS:87-51-4,3-吲哚乙酸(IAA)
CAS:367-93-1,异丙基-β-D-硫代半乳糖苷,IPTG
食用靛蓝色素,食用靛蓝价格
CAS:830-96-6,3-吲哚丙酸(IPA)
CAS:133-32-4,3-吲哚丁酸,吲哚丁酸使用方法
古朵生物,专业供应科研实验所需的培养基,抗体,动物血清血浆,标准品对照品,化学试剂,酶联免疫试剂盒,白介素试剂盒,金标检测试剂盒,微生物,蛋白质,ELISA种属涵盖广,凭借多年行业经验,完善的售后服务,高质量的产品,赢得客户一致好评,欢迎来电咨询与订购!